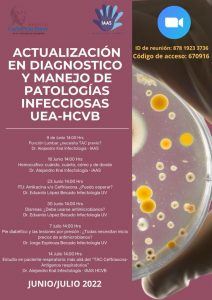

Ministerios Gobierno de Chile
- Ministerio de Bienes Nacionales
- Ministerio de Minería
- Ministerio del Interior y Seguridad Pública
- Ministerio del Medio Ambiente
- Consejo Nacional de la Cultura y las Artes
- Ministerio del Deporte
- Ministerio de Vivienda y Urbanismo
- Ministerio de Energía
- Ministerio Secretaría General de la Presidencia
- Ministerio de Hacienda
- Ministerio de Economía, Fomento y Turismo
- Ministerio de Educación
- Ministerio del Trabajo y Previsión Social
- Ministerio de Justicia
- Ministerio de Obras Públicas
- Ministerio de Relaciones Exteriores
- Ministerio de Defensa Nacional
- Ministerio Secretaría General de Gobierno
- Ministerio del Desarrollo Social
- Ministerio de Salud
- Ministerio de Agricultura
- Ministerio de Transporte y Telecomunicaciones
- Servicio Nacional de la Mujer